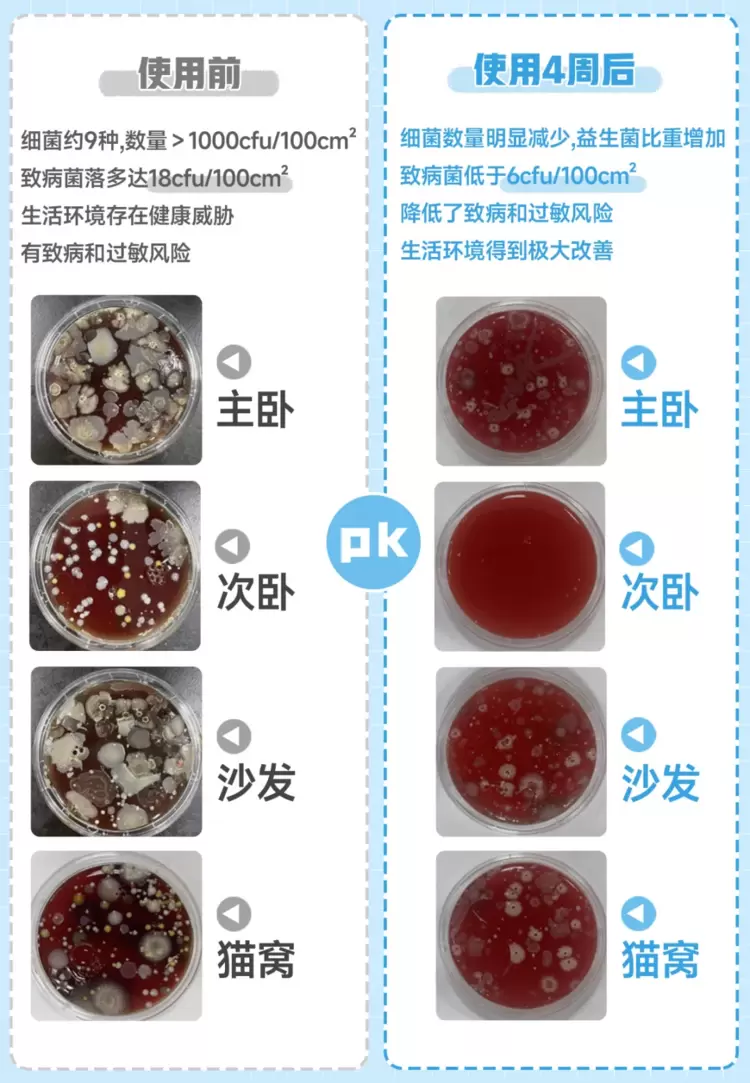

揭秘悦呼吸环境益生菌魔力:养宠家庭环境改善实测报告
2024-04-08 14:56:18AI云资讯1372
宠物成为越来越多家庭的一员
居家环境的卫生与健康问题也日益受到关注
悦呼吸近期对一户【养宠家庭】
进行了为期一个月的居家环境检测
重点关注了主卧、次卧、沙发和猫窝等关键区域

悦呼吸主要通过采用【血琼脂接触皿按压法】采集样本,并依据菌落形态观察法进行评估,我们得到了一系列真实数据。
使用悦呼吸全净器前
该家庭的细菌数量高达每一百平方厘米超过1000个菌落(cfu),种类多达9种。致病菌落数量达到了每一百平方厘米18个,这无疑增加了家庭成员感染疾病的风险。

此外,每一百平方厘米螨虫数量超过了500只,这些微小的生物极易诱发过敏反应,对家人的健康构成威胁。

使用悦呼吸全净器四周后
居家环境中的悦呼吸益生菌占比明显增加,细菌数量大幅减少,致病菌数量更是低于每一百平方厘米6cfu。生活环境得到极大改善,很大程度降低了致病风险。
螨虫数量也得到了有效控制,从每一百平方厘米螨虫数量超过500只,降到每一百平方厘米20只以下,从根源降低了过敏风险。

悦呼吸全净器净化原理
悦呼吸全净器每次喷洒的500万个环境益生菌
能覆盖物体表面及深入物体内部
——
以致病菌等有害物质为营养来源,进行生长繁殖
并占据致病菌的生长空间
争夺致病菌的营养、产生小分子抑菌化合物
有效抑制室内环境中的致病菌

还能产生大量蛋白酶类物质
降解环境中常见的引起过敏的蛋白类过敏原
并利用降解物进行生长繁殖
从根源上分解掉螨虫、猫狗等过敏原(均属于蛋白类过敏原)

通过这次深度居家环境检测,可以充分证明悦呼吸全净器每次喷洒的环境益生菌在改善养宠家庭生活环境方面的强大实力。

悦呼吸全净器不仅能有效去除养宠家庭中的细菌、病毒和过敏原,还能平衡室内微生态,为家人和宠物创造一个更健康、更舒适的生活空间。
相关文章
- 欣诺环境碳(CO2)捕集中试平台正式落成投运
- 保护环境 钓获放流丨2026阿玛迪斯“爱鱼仕”评选活动即将启幕
- 光明园迪:以器物之美,承载环境育人之责
- 深度解码普宙科技P300无人机:复杂环境下的“全能王者”
- 三维天地推出SaaS版LIMS,加速生态环境检测机构合规化进程
- Soul打造年轻人的社交元宇宙,提供自在线上社交环境
- 《检验检测机构资质认定生态环境监测机构评审补充要求(2025年)》分析及LIMS方案优化
- 优化厅店环境 黄冈联通以极致服务暖人心
- 三维天地AI+监管平台重塑环境检测新生态
- 宜昌联通定制化服务赋能生态环境保护综合执法支队
- 荆门联通深化“静音行动+”让通讯环境更清净
- 伽利略智能仿生四足防爆机器人EX-1重磅亮相2025中国国际应急管理展览会开创高危环境智能作业新纪元
- 联通好服务 用心为客户——北京联通持续提升企业客户服务水平 为首都营商环境注入“数字加速度”
- 反诈助老暖人心 环境焕新惠民生 ——鄂州联通开展银发族专项会员日活动
- lipro 健康照明携手美的全屋智能,重塑智能家居健康光环境
- “法治化营商环境护航民营经济高质量发展”研讨会在洛阳举办
人工智能企业
更多>>人工智能硬件
更多>>人工智能产业
更多>>人工智能技术
更多>>- 高德发布鸿蒙首个生成式 UI 开源框架 AGenUI,告别传统 UI 开发模式
- 发布即适配| 天数智芯全力支持腾讯混元Hy3 preview 开源落地,共推国内大模型产业普惠
- Seedance 2.0面向企业公测,豆包大模型日均Token使用量突破120万亿
- 端到端OCR模型第一!百度千帆Qianfan-OCR正式发布
- 云知声Unisound U1-OCR大模型发布!首个工业级文档智能基础大模型,开启OCR 3.0时代
- 基石智算上线 MiniMax M2.5,超强编程与智能体工具调用能力
- 昇腾原生支持,科学多模态大模型Intern-S1-Pro正式发布并开源
- 百度千帆深度研究Agent登顶权威评测榜单DeepResearch Bench









